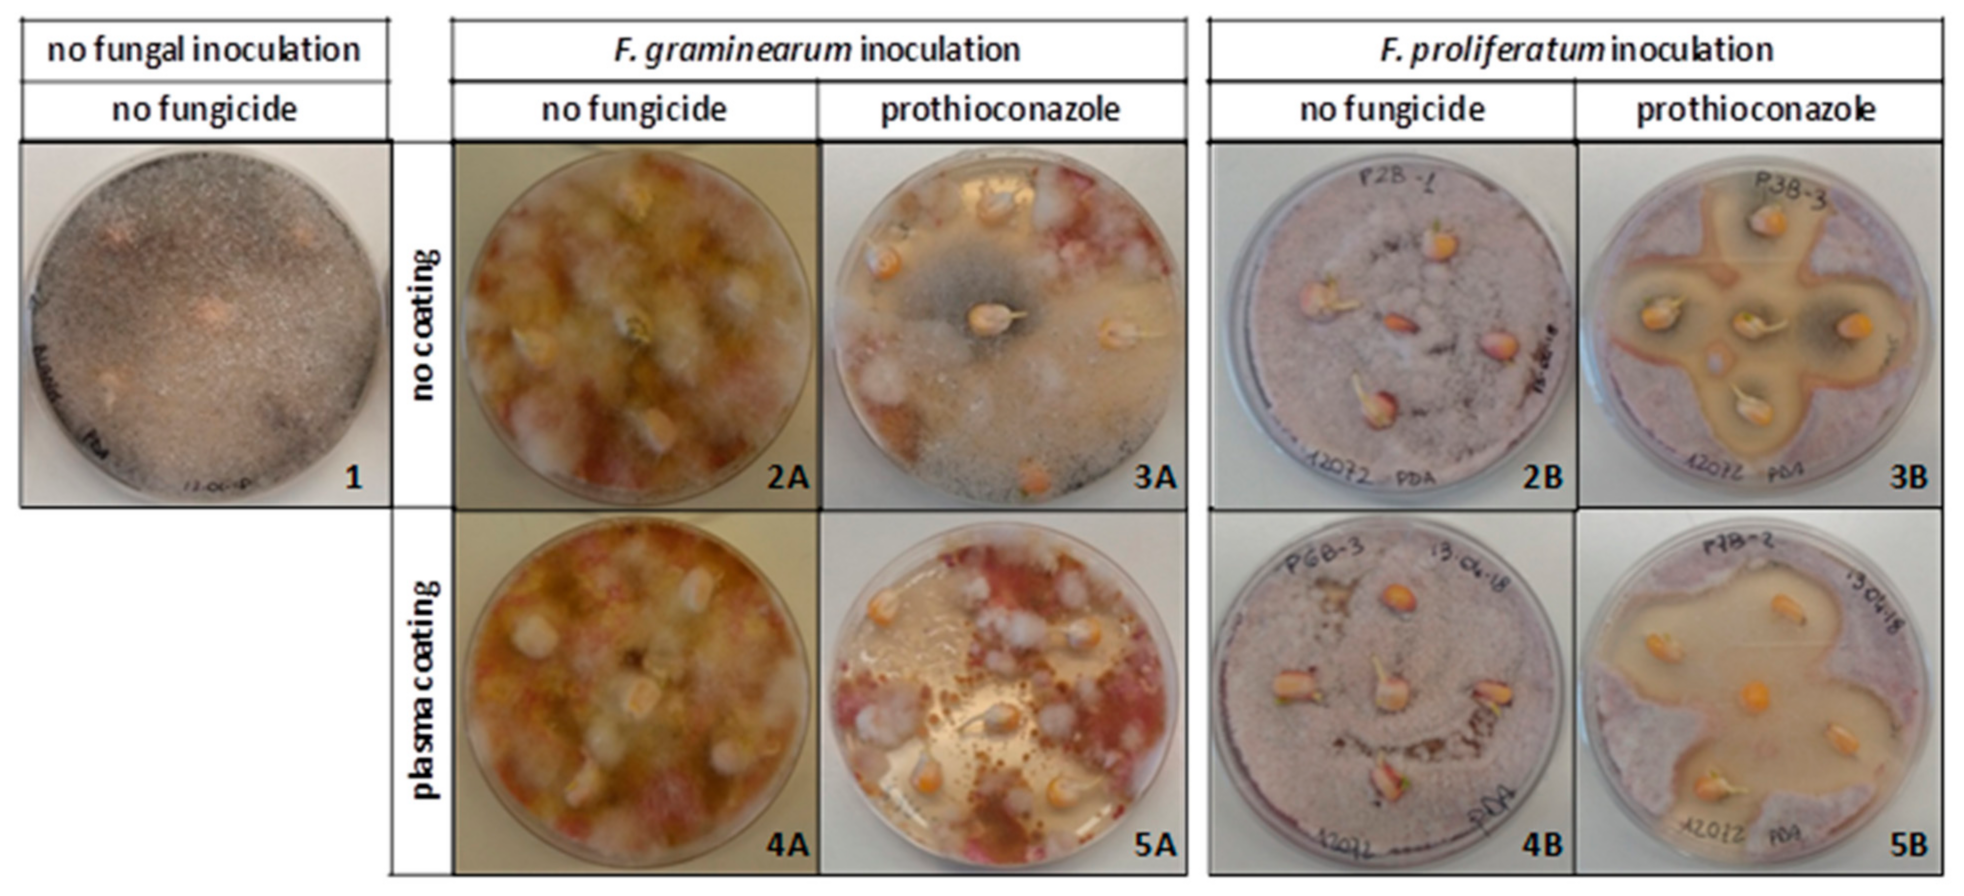
Ijms 22 09301 g001 550

Plasma Technology Increases the Efficacy of Prothioconazole against Fusarium graminearum and Fusarium proliferatum Contamination of Maize (Zea mays) Seedlings
Abstract
:1. Introduction
2. Results
2.1. In Vitro Effect of Plasma Coating and Prothioconazole Application, Alone or in Combination, against Fusarium Species
2.1.1. Seed Germination
2.1.2. Transmission of the Fungi to Roots and Stems
2.2. In Planta Effects of Plasma Coating and Prothioconazole Application
2.2.1. Seed Germination
2.2.2. Colonization of Roots and Stems
2.2.3. Disease Symptoms on Seedlings
3. Discussion
4. Materials and Methods
4.1. Maize Kernels, Fungicide Application, and Plasma-Deposited Coatings
4.2. Fungal Strains and Preparation of Inoculum
4.3. In Vitro Experimental Assays
4.4. In Planta Experimental Trials in Phytotron
4.5. Statistical Analyses
5. Conclusions
Author Contributions
Funding
Institutional Review Board Statement
Informed Consent Statement
Data Availability Statement
Acknowledgments
Conflicts of Interest
References
- Edgerton, M.D. Increasing crop productivity to meet global needs for feed, food, and fuel. Plant Physiol. 2009, 149, 7–13. [Google Scholar] [CrossRef] [PubMed] [Green Version]
- Orhun, G.E. Maize for Life. Int. J. Food Sci. Nutr. Eng. 2013, 3, 13–16. [Google Scholar] [CrossRef]
- Oldenburg, E.; Höppner, F.; Ellner, F.; Weinert, J. Fusarium diseases of maize associated with mycotoxin contamination of agricultural products intended to be used for food and feed. Mycotoxin Res. 2017, 33, 167–182. [Google Scholar] [CrossRef] [PubMed]
- Logrieco, A.; Mulè, G.; Moretti, A.; Bottalico, A. Toxigenic Fusarium Species and Mycotoxins Associated with Maize Ear Rot in Europe. Eur. J. Plant Pathol. 2002, 108, 597–609. [Google Scholar] [CrossRef]
- Blacutt, A.A.; Gold, S.E.; Voss, K.A.; Gao, M.; Glenn, A.E. Fusarium verticillioides: Advancements in understanding the toxicity, virulence, and niche adaptations of a model mycotoxigenic pathogen of maize. Phytopathology 2018, 108, 312–326. [Google Scholar] [CrossRef] [PubMed] [Green Version]
- Gai, X.; Dong, H.; Wang, S.; Liu, B.; Zhang, Z.; Li, X.; Gao, Z. Infection cycle of maize stalk rot and ear rot caused by Fusarium verticillioides. PLoS ONE 2018, 13, e0201588. [Google Scholar] [CrossRef] [PubMed]
- Munkvold, G.P.; Carlton, W.M. Influence of inoculation method on systemic Fusarium moniliforme infection of maize plants grown from infected seeds. Plant Dis. 1997, 81, 211–216. [Google Scholar] [CrossRef] [Green Version]
- Munkvold, G.P.; Desjardins, A.E. Fumonisins in maize: Can we reduce their occurrence? Plant Dis. 1997, 81, 556–565. [Google Scholar] [CrossRef] [Green Version]
- Fallahi, M.; Saremi, H.; Javan-Nikkhah, M.; Somma, S.; Haidukowski, M.; Logrieco, A.F.; Moretti, A. Isolation, Molecular Identification and Mycotoxin Profile of Fusarium Species Isolated from Maize Kernels in Iran. Toxins 2019, 11, 297. [Google Scholar] [CrossRef] [Green Version]
- Zhou, D.; Wang, X.M.; Chen, G.K.; Sun, S.; Yang, Y.; Zhu, Z.D.; Duan, C.X. The major Fusarium species causing maize ear and kernel rot and their toxigenicity in Chongqing, China. Toxins 2018, 10, 90. [Google Scholar] [CrossRef] [Green Version]
- Marín, S.; Magan, N.; Ramos, A.J.; Sanchis, V. Fumonisin-Producing Strains of Fusarium: A Review of Their Ecophysiology. J. Food Prot. 2004, 67, 1792–1805. [Google Scholar] [CrossRef] [PubMed]
- Logrieco, A.; Moretti, A.; Ritieni, A.; Bottalico, A.; Corda, P. Occurrence and toxigenicity of Fusarium proliferatum from preharvest maize ear rot, and associated mycotoxins in Italy. Plant Dis. 1995, 79, 727–731. [Google Scholar] [CrossRef]
- Proctor, R.H.; Desjardins, A.E.; Moretti, A. Biological and chemical complexity of Fusarium proliferatum. In The Role of Plant Pathology in Food Safety and Food Security; Springer: Dordrecht, The Netherlands, 2009; pp. 97–111. [Google Scholar]
- Marasas, W.F.O.; Thiel, P.G.; Rabie, C.J.; Nelson, P.E.; Toussoun, T.A. Moniliformin production in Fusarium section Liseola. Mycologia 1986, 78, 242–247. [Google Scholar] [CrossRef]
- Moretti, A.; Logrieco, A.; Bottalico, A.; Ritieni, A.; Randazzo, G. Production of beauvericin by Fusarium proliferatum from maize in Italy. Mycotoxin Res. 1994, 10, 73–78. [Google Scholar] [CrossRef] [PubMed]
- Ritieni, A.; Fogliano, V.; Randazzo, G.; Scarallo, A.; Logrieco, A.; Moretti, A.; Mannina, L.; Bottalico, A. Isolation and characterization of fusaproliferin, a new toxic metabolite from Fusarium proliferatum. Nat. Toxins 1995, 3, 17–20. [Google Scholar] [CrossRef]
- Miller, J.D.; Savard, M.E.; Schaafsma, A.W.; Seifert, K.A.; Reid, L.M. Mycotoxin production by Fusarium moniliforme and Fusarium proliferatum from Ontario and occurrence of fumonisin in the 1993 corn crop. Can. J. Plant Pathol. 1995, 17, 233–239. [Google Scholar]
- Pfordt, A.; Romero, L.R.; Schiwek, S.; Karlovsky, P.; von Tiedemann, A. Impact of Environmental Conditions and Agronomic Practices on the Prevalence of Fusarium Species Associated with Ear- and Stalk Rot in Maize. Pathogens 2020, 9, 236. [Google Scholar] [CrossRef] [Green Version]
- Murillo-Williams, A.; Munkvold, G.P. Systemic infection by Fusarium verticillioides in maize plants grown under three temperature regimes. Plant Dis. 2008, 92, 1695–1700. [Google Scholar] [CrossRef] [Green Version]
- Weltmann, K.D.; Kolb, J.F.; Holub, M.; Uhrlandt, D.; Simek, M.; Ostrikov, K.; Hamaguchi, S.; Cvelbar, U.; Cernak, M.; Locke, B.; et al. The future in Plasma Science and Technology. Plasma Process. Polym. 2019, 16, e1800118. [Google Scholar] [CrossRef] [Green Version]
- Bekeschus, S.; Favia, P.; Robert, E.; von Woedtke, T. White paper on plasma for medicine and hygiene: Future in plasma health sciences. Plasma Process. Polym. 2019, 16, e1800033. [Google Scholar] [CrossRef] [Green Version]
- Trizio, I.; Trulli, M.G.; Lo Porto, C.; Pignatelli, D.; Camporeale, G.; Palumbo, F.; Sardella, E.; Gristina, R.; Favia, P. Plasma Processes for Life Sciences. In Elsevier Reference Module in Chemistry, Molecular Sciences and Chemical Engineering; Reedijk, J., Ed.; Elsevier: Waltham, MA, USA, 2018. [Google Scholar] [CrossRef]
- Khatami, S.; Ahmadinia, A. Increased germination and growth rates of pea and Zucchini seed by FSG plasma. J. Theor. Appl. Phys. 2018, 12, 33–38. [Google Scholar] [CrossRef] [Green Version]
- Kumar, R.; Singh, P.; Kumar, S. Plasma Treatment—A Tool to Improve Seed Quality—A Review. Adv. Res. 2017, 12, 1–6. [Google Scholar] [CrossRef]
- Sivachandiran, L.; Khacef, A. Enhanced seed germination and plant growth by atmospheric pressure cold air plasma: Combined effect of seed and water treatment. RSC Adv. 2017, 7, 1822–1832. [Google Scholar] [CrossRef] [Green Version]
- Brasoveanu, M.; Nemtanu, M.R.; Surdu-Bob, C.; Karaca, G.; Erper, I. Effect of Glow Discharge Plasma on Germination and Fungal Load of Some Cereal Seeds. Rom. Rep. Phys. 2015, 67, 617–624. [Google Scholar]
- Filatova, I.; Azharonok, V.; Lushkevich, V.; Zhukovsky, A.; Spasić, K.; Živković, S.; Puač, N.; Lazović, S.; Malović, G.; Petrović, Z. Plasma seeds treatment as a promising technique for seed germination improvement. In Proceedings of the 31st ICPIG, Granada, Spain, 14–19 July 2013; Available online: http://icpig2013.net/papers/127_2.pdf (accessed on 9 June 2021).
- Casas-Junco, P.P.; Solís-Pacheco, J.R.; Ragazzo-Sánchez, J.A.; Aguilar-Uscanga, B.R.; Bautista-Rosales, P.U.; Calderón-Santoyo, M. Cold Plasma Treatment as an Alternative for Ochratoxin a Detoxification and Inhibition of Mycotoxigenic Fungi in Roasted Coffee. Toxins 2019, 11, 337. [Google Scholar] [CrossRef] [Green Version]
- Zahoranova, A.; Hoppanova, L.; Simoncicova, J.; Tuekova, Z.; Medvecka, V.; Hudecova, D.; Kaliňáková, B.; Kováčik, D.; Černák, M. Effect of cold atmospheric pressure plasma on maize seeds: Enhancement of seedlings growth and surface microorganisms inactivation. Plasma Chem. Plasma Process. 2018, 38, 969–988. [Google Scholar] [CrossRef]
- Jo, Y.K.; Cho, J.; Tsai, T.C.; Staack, D.; Kang, M.H.; Roh, J.H.; Shin, D.B.; Cromwell, W.; Gross, D. A non-thermal plasma seed treatment method for management of a seedborne fungal pathogen on rice seed. Crop Sci. 2014, 54, 796–803. [Google Scholar] [CrossRef]
- Puač, N.; Gherardi, M.; Shiratani, M. Plasma agriculture: A rapidly emerging field. Plasma Process. Polym. 2018, 15, e1700174. [Google Scholar] [CrossRef]
- Lo Porto, C.; Palumbo, F.; Somma, S.; Masiello, M.; Moretti, A.; Fracassi, F.; Favia, P. Plasma-assisted deposition of fungicide containing coatings for encapsulation and protection of maize seeds. Plasma Process. Polym. 2019, 16, e1900022. [Google Scholar] [CrossRef]
- Masiello, M.; Somma, S.; Ghionna, V.; Logrieco, A.F.; Moretti, A. In Vitro and in Field Response of Different Fungicides against Aspergillus flavus and Fusarium Species Causing Ear Rot Disease of Maize. Toxins 2019, 11, 11. [Google Scholar] [CrossRef] [Green Version]
- Da Ponte, G.; Sardella, E.; Fanelli, F.; Van Hoeck, A.; d’Agostino, R.; Paulussen, S.; Favia, P. Atmospheric Plasma Deposition of different organic films for biomedical applications. Surf. Coat. Technol. 2011, 205, S525. [Google Scholar] [CrossRef]
- Da Ponte, G.; Sardella, E.; Fanelli, F.; d’Agostino, R.; Favia, P. Trends in surface engineering of biomaterials: Atmospheric pressure plasma deposition of coatings for biomedical applications. Eur. Phys. J.-Appl. Physics 2011, 56, 24023. [Google Scholar] [CrossRef] [Green Version]
- Duthie, J.A.; Hall, R. Transmission of Fusarium graminearum from seeds to stems of winter wheat. Plant Pathol. 1987, 36, 3337. [Google Scholar] [CrossRef]
- Moretti, A.; Panzarini, G.; Somma, S.; Campagna, C.; Ravaglia, S.; Logrieco, A.F.; Solfrizzo, M. Systemic growth of F. graminearum in wheat plants and related accumulation of deoxynivalenol. Toxins 2014, 6, 1308–1324. [Google Scholar] [CrossRef] [PubMed] [Green Version]
- Kabeere, F.; Hampton, J.G.; Hill, M.J. Transmission of Fusarium graminearum (Schwabe) from maize seeds to seedlings. Seed Sci. Technol. 1997, 25, 245–252. [Google Scholar]
- Burlakoti, R.R.; Burlakoti, P. Management of maize ear rot complex caused by Fusarium species in field using host resistance and seeds treatment chemicals. J. Crop Prot. 2015, 4, 453–462. [Google Scholar]
- Munkvold, G.P.; O’Mara, J.K. Laboratory and growth chamber evaluation of fungicidal seed treatments for maize seedling blight caused by Fusarium species. Plant Dis. 2002, 86, 143–150. [Google Scholar] [CrossRef] [Green Version]
- Rodriguez-Brljevich, C.; Kanobe, C.; Shanahan, J.F.; Robertson, A.E. Seed treatments enhance photosynthesis in maize seedlings by reducing infection with Fusarium spp. and consequent disease development in maize. Eur. J. Plant Pathol. 2010, 126, 343–347. [Google Scholar] [CrossRef] [Green Version]
- Galperin, M.; Graf, S.; Kenigsbuch, D. Seeds treatment prevents vertical transmission of Fusarium moniliforme, making a significant contribution to disease control. Phytoparasitica 2003, 31, 344–352. [Google Scholar] [CrossRef]
- Siciliano, I.; Spadaro, D.; Prelle, A.; Vallauri, D.; Cavallero, M.C.; Garibaldi, A.; Gullino, M.L. Use of cold atmospheric plasma to detoxify hazelnuts from aflatoxins. Toxins 2016, 8, 125. [Google Scholar] [CrossRef]
- Ouf, S.A.; Mohamed, A.A.H.; El-Sayed, W.S. Fungal Decontamination of Fleshy Fruit Water Washes by Double Atmospheric Pressure Cold Plasma. CLEAN-Soil Air Water 2015, 44, 134–142. [Google Scholar] [CrossRef]
- Basaran, P.; Basaran-Akgul, N.; Oksuz, L. Elimination of Aspergillus parasiticus from nut surface with low pressure cold plasma (LPCP) treatment. Food Microbiol. 2008, 25, 626–632. [Google Scholar] [CrossRef] [PubMed]

| Theses | Fungal Inoculation | Seed Coating | Fungicide Application |
|---|---|---|---|
| 1 | not inoculated | No | No |
| 2A | F. graminearum | No | No |
| 3A | No | Prothioconazole | |
| 4A | Plasma coating | No | |
| 5A | Plasma coating | Prothioconazole | |
| 2B | F. proliferatum | No | No |
| 3B | No | Prothioconazole | |
| 4B | Plasma coating | No | |
| 5B | Plasma coating | Prothioconazole |
Publisher’s Note: MDPI stays neutral with regard to jurisdictional claims in published maps and institutional affiliations. |
© 2021 by the authors. Licensee MDPI, Basel, Switzerland. This article is an open access article distributed under the terms and conditions of the Creative Commons Attribution (CC BY) license (https://creativecommons.org/licenses/by/4.0/).
Share and Cite
Masiello, M.; Somma, S.; Lo Porto, C.; Palumbo, F.; Favia, P.; Fracassi, F.; Logrieco, A.F.; Moretti, A. Plasma Technology Increases the Efficacy of Prothioconazole against Fusarium graminearum and Fusarium proliferatum Contamination of Maize (Zea mays) Seedlings. Int. J. Mol. Sci. 2021, 22, 9301. https://doi.org/10.3390/ijms22179301
Masiello M, Somma S, Lo Porto C, Palumbo F, Favia P, Fracassi F, Logrieco AF, Moretti A. Plasma Technology Increases the Efficacy of Prothioconazole against Fusarium graminearum and Fusarium proliferatum Contamination of Maize (Zea mays) Seedlings. International Journal of Molecular Sciences. 2021; 22(17):9301. https://doi.org/10.3390/ijms22179301
Chicago/Turabian StyleMasiello, Mario, Stefania Somma, Chiara Lo Porto, Fabio Palumbo, Pietro Favia, Francesco Fracassi, Antonio Francesco Logrieco, and Antonio Moretti. 2021. "Plasma Technology Increases the Efficacy of Prothioconazole against Fusarium graminearum and Fusarium proliferatum Contamination of Maize (Zea mays) Seedlings" International Journal of Molecular Sciences 22, no. 17: 9301. https://doi.org/10.3390/ijms22179301
APA StyleMasiello, M., Somma, S., Lo Porto, C., Palumbo, F., Favia, P., Fracassi, F., Logrieco, A. F., & Moretti, A. (2021). Plasma Technology Increases the Efficacy of Prothioconazole against Fusarium graminearum and Fusarium proliferatum Contamination of Maize (Zea mays) Seedlings. International Journal of Molecular Sciences, 22(17), 9301. https://doi.org/10.3390/ijms22179301

